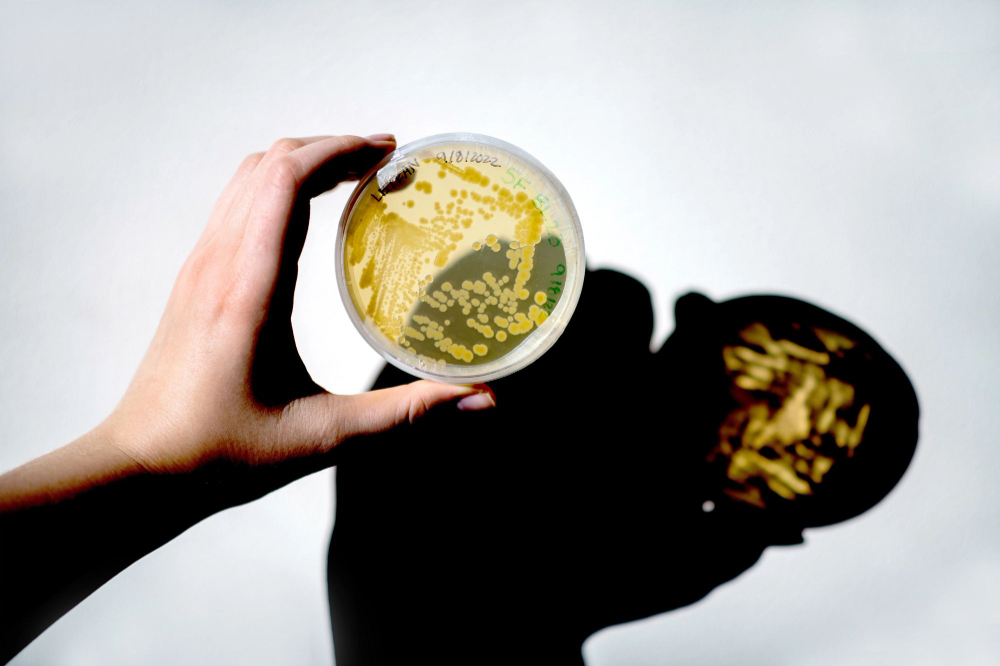

Chemistry
Bachelor of Science (B.S.)
Undergraduate Major
Allendale • Face to face • 172 Credits
Undergraduate Major
Allendale • Face to face • 172 Credits
Chemistry is the scientific study of properties, composition, and behavior of matter, exploring how substances interact, combine, and change to form new materials.
This program is designed to give students a thorough grounding in all five major areas of chemistry: organic, inorganic, analytical, physical, and biochemistry. The curriculum emphasizes both theoretical understanding and practical laboratory skills, preparing students for diverse careers in industries such as pharmaceuticals, environmental science, and materials science. Students also have opportunities to engage in research projects, working alongside faculty on innovative chemical investigations.
You will take courses in all five areas of chemistry and choose from electives like sustainable chemistry and electrochemistry while studying related subjects like calculus and physics. These courses are designed to build a strong foundation in chemical principles while developing advanced skills in laboratory techniques and instrumentation. The program offers flexibility for course substitutions and includes options for American Chemical Society (ACS) certification through additional lab hours and upper-level electives.
Beyond the freshman year:
Programs are certified by the Committee on Professional Training of the American Chemical Society.
gvsu.edu/chem
312 Padnos
Hall
(616) 331-3317
Admissions and Recruitment Office
Research and study the structures and chemical properties of various natural and synthetic or composite materials, including metals, alloys, rubber, ceramics, semiconductors, polymers, and glass. Determine ways to strengthen or combine materials or develop new materials with new or specific properties for use in a variety of products and applications. Includes glass scientists, ceramic scientists, metallurgical scientists, and polymer scientists.
Top skills| Annual Earnings | Percentile |
|---|---|
| $ 55,189.53 | 10% |
| $ 70,868.86 | 25% |
| $ 93,547.68 | 50% |
| $128,894.36 | 75% |
| $162,772.87 | 90% |
Plan, direct, or coordinate activities in such fields as life sciences, physical sciences, mathematics, statistics, and research and development in these fields.
Top skills| Annual Earnings | Percentile |
|---|---|
| $ 81,785.59 | 10% |
| $104,083.20 | 25% |
| $135,179.19 | 50% |
| $178,235.20 | 75% |
| $239,200.00 | 90% |
Use chemistry, microbiology, engineering, and other sciences to study the principles underlying the processing and deterioration of foods; analyze food content to determine levels of vitamins, fat, sugar, and protein; discover new food sources; research ways to make processed foods safe, palatable, and healthful; and apply food science knowledge to determine best ways to process, package, preserve, store, and distribute food.
Top skills| Annual Earnings | Percentile |
|---|---|
| $ 57,352.81 | 10% |
| $ 62,892.69 | 25% |
| $ 84,706.05 | 50% |
| $125,086.14 | 75% |
| $157,532.22 | 90% |
Conduct research or perform investigation for the purpose of identifying, abating, or eliminating sources of pollutants or hazards that affect either the environment or public health. Using knowledge of various scientific disciplines, may collect, synthesize, study, report, and recommend action based on data derived from measurements or observations of air, food, soil, water, and other sources.
Top skills| Annual Earnings | Percentile |
|---|---|
| $ 49,969.93 | 10% |
| $ 60,943.02 | 25% |
| $ 76,684.68 | 50% |
| $ 96,560.35 | 75% |
| $108,792.32 | 90% |
Conduct chemical and physical laboratory tests to assist scientists in making qualitative and quantitative analyses of solids, liquids, and gaseous materials for research and development of new products or processes, quality control, maintenance of environmental standards, and other work involving experimental, theoretical, or practical application of chemistry and related sciences.
Top skills| Annual Earnings | Percentile |
|---|---|
| $ 39,501.27 | 10% |
| $ 46,303.24 | 25% |
| $ 57,681.31 | 50% |
| $ 66,635.28 | 75% |
| $ 80,834.06 | 90% |
Careers are a great way to get paid after graduation. The Career Center and your faculty advisor can help you find the right career for you.
We're here to help you make the most of your college experience. Join any of our hundreds of student organizations, attend campus events, get involved in Fraternity & Sorority Life, explore civic engagement opportunities, and learn valuable leadership skills that will last a lifetime.
Grand Valley State University offers a wide variety of merit-based scholarships. For information on all of the scholarships that are available to students, please visit Scholarships at GVSU.